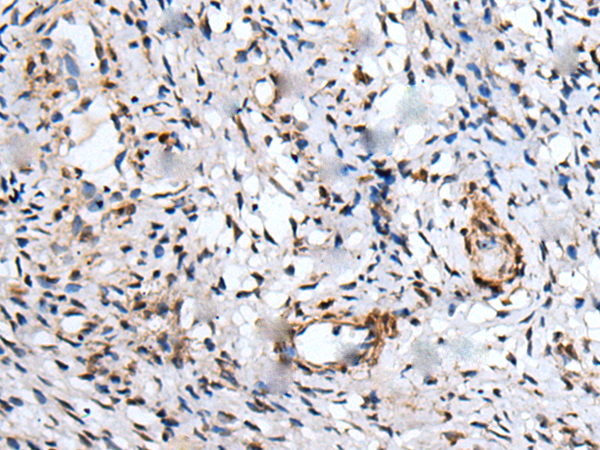

中文名稱: 兔抗UBE2W多克隆抗體
|
Background: |
This gene encodes a nuclear-localized ubiquitin-conjugating enzyme (E2) that, along with ubiquitin-activating (E1) and ligating (E3) enzymes, coordinates the addition of a ubiquitin moiety to existing proteins. The encoded protein promotes the ubiquitination of Fanconi anemia complementation group proteins and may be important in the repair of DNA damage. There is a pseudogene for this gene on chromosome 1. Alternative splicing results in multiple transcript variants. |
|
Applications: |
ELISA, IHC |
|
Name of antibody: |
UBE2W |
|
Immunogen: |
Full length fusion protein |
|
Full name: |
ubiquitin conjugating enzyme E2W (putative) |
|
Synonyms: |
UBC16; UBC-16 |
|
SwissProt: |
Q96B02 |
|
ELISA Recommended dilution: |
5000-10000 |
|
IHC positive control: |
Human lung cancer and human liver cancer |
|
IHC Recommend dilution: |
25-100 |

購(gòu)物車
購(gòu)物車 幫助
幫助
 021-54845833/15800441009
021-54845833/15800441009
